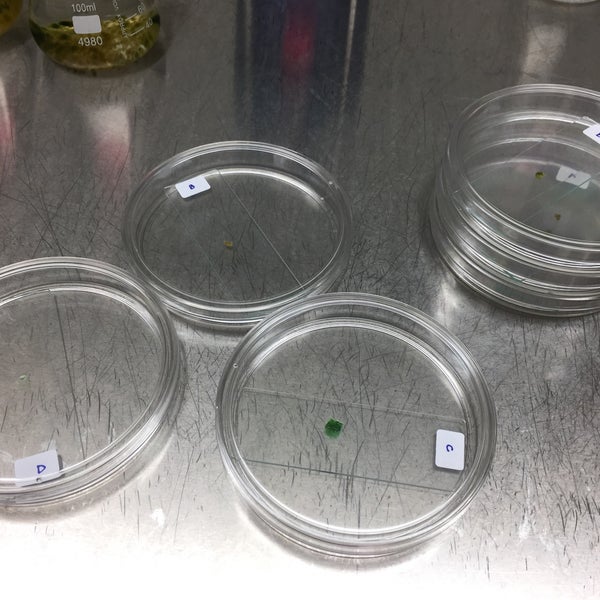

C2 Lab
Sleipnir Dildo
Men Free Chat
Backpage Houston Southwest
Lesbea HD Piper Fawn teased then licked to orgasm
Sex Hardcore Fucking Ass
Candice Dare gets spanked and fucked by a badass masseur
Julia Ann Sex Video
Pornhub Taxi
Kasumi Uehara - 10 Glamorous Japanese PornStar
Sarah Shevon Interracial Assfuck
Young Hairy Pussy
Mature woman shoes socks fan photo
Hd Clips Porn Video Mom
C2 Lab 108 photos